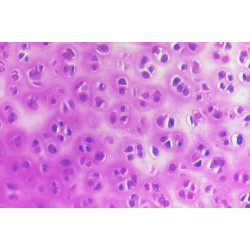
COLECCIÓN DE PREPARACIONES BIOLOGÍA GENERAL. 25 UNIDADES

Contacto - 91 005 91 70 / 91 776 87 11 - info@ibdciencia.com - Pide tu presupuesto
COLECCIÓN DE PREPARACIONES BIOLOGÍA GENERAL. 25 UNIDADES
Estructuras, tejidos y órganos animales y vegetales
47,59 €
(iva inc.)
Referencia:
PR1056
Muscular estriado Bacterias del yogurt
Cartílago hialino Pulmón
Ovario vegetal Cartílago elástico
Intestino delgado Ganglio linfático
Raíz dicotiledónea Lengua de mamífero
Espículas de esponja Arteria
Estómago mamífero Almidón
Células pétreas Ráfides
Ascomicete Tallo dicotiledónea
Polen Hidroideos
Hoja eucaliptus Pelo de perro
Escama ctenoidea Pata de mosca.
Sangre de ave